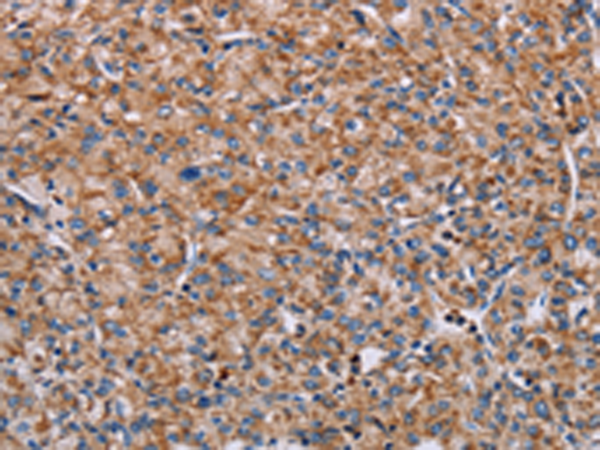
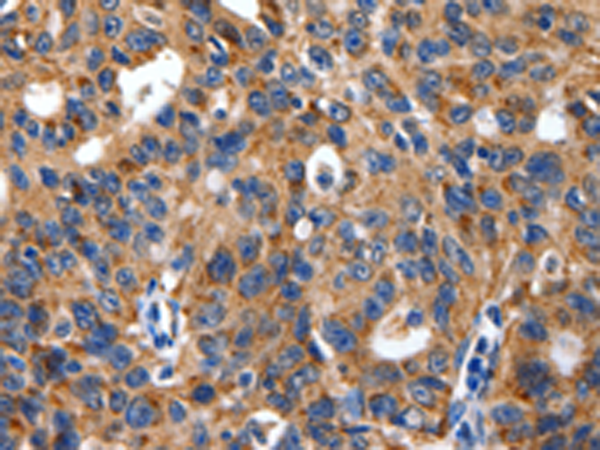
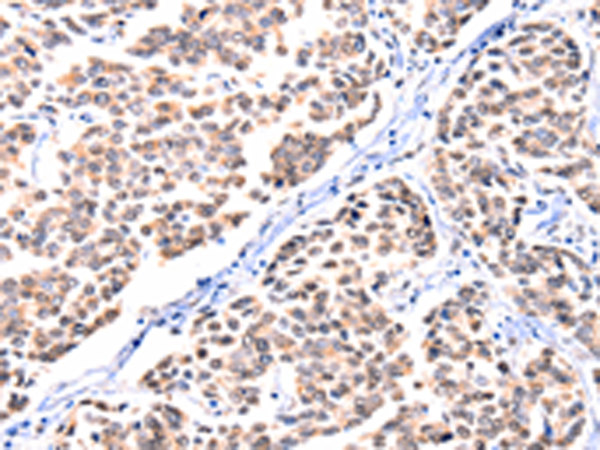
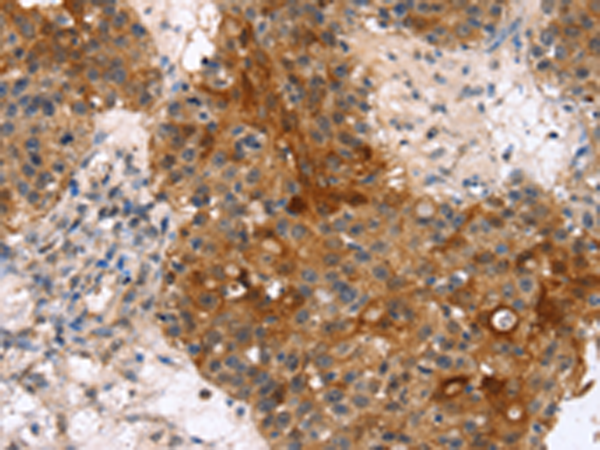

-
分类: 科研抗体货号: P10853别名: ALXR, HM63, FMLPX, FPR2A, FPRH1, FPRH2, FPRL1, LXA4R, FMLP-R-II应用: IHC反应种属: Human
-
分类: 科研抗体货号: P10813别名: SAG; GP340; SALSA; muclin应用: IHC反应种属: Human, Mouse, Rat
-
分类: 科研抗体货号: P10832别名: ALK-SMase应用: IHC反应种属: Human, Rat
-
分类: 科研抗体货号: P10851别名: EVEC; UP50; ADCL2; ARMD3; DANCE; ARCL1A; FIBL-5; HNARMD应用: IHC反应种属: Human, Mouse, Rat
-
分类: 科研抗体货号: P10843别名: HB5; HVH8; HVH-5; C11orf81应用: WB,IHC反应种属: Human, Mouse
-
分类: 科研抗体货号: P10831别名: B10, NPP3, PDNP3, CD203c, PD-IBETA应用: IHC反应种属: Human, Mouse, Rat
-
分类: 科研抗体货号: P10850别名: FBLN, FIBL1应用: IHC反应种属: Human
-
分类: 科研抗体货号: P10842别名: ERK4; ERK-4; PRKM4; p63MAPK; p63-MAPK应用: WB,IHC反应种属: Human, Mouse
-
分类: 科研抗体货号: P10830别名: SARP3应用: IHC反应种属: Human, Mouse
-
分类: 科研抗体货号: P10849别名: ACH, CEK2, JTK4, CD333, HSFGFR3EX应用: IHC反应种属: Human, Mouse

鄂公网安备42018502007531号
鄂公网安备42018502007531号

